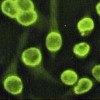

Другие названия и синонимы
Antinuclear antibodies (ANA).
Описание
Антиядерные антитела (АНА, АНА). Специфические иммуноглобулины, которые связываются с компонентами клеточных ядер собственного организма. Определяется в плазме при ревматических заболеваниях, первичном билиарном циррозе, злокачественных опухолях, инфекциях. Исследование используется для диагностики и дифференциации аутоиммунных заболеваний в контексте скрининга и представления характерных клинических признаков. Кровь взята из вены. Анализ проводится тремя способами: методом иммуноферментного анализа (определяется общий уровень АНА), методом иммуноблота и косвенной иммунофлуоресцентной реакцией (обнаружено до 15 типов АНА). Обычно результат отрицательный. Продолжительность теста с ИФА составляет 1 день, с иммуноблоттингом, ИИФ - 8 дней.
|
|
Дополнительные факты
Обычно клетки мертвого тела фагоцитируются макрофагами. При аутоиммунном заболевании возникает не только использование клеточных компонентов (ядрышки, гистоны, ядра), но и передача информации о них в структуре иммунного ответа. В-лимфоциты запускают выработку антител против ядерных антигенов. Полученные иммунные комплексы фиксируются в базальных мембранах сосудов и органов крови, активируется система комплемента и развивается местное воспаление. Исследование ANA с использованием иммуноферментного анализа имеет низкую специфичность, но является экономичным с точки зрения времени и трудозатрат. Иммуноблоттинг и метод RNIF предоставляют очень специфическую информацию, но их распространение ограничено трудоемкостью и высокой стоимостью процедуры.

Показания к применению
Тест на антиядерные антитела назначают при аутоиммунных заболеваниях. Показания к общему определению IgG, IgM, IgA с помощью ИФА:
• Скрининг на коллагеноз. Тест используется для обследования людей с риском неспецифических и легких симптомов: усталости, лихорадки, головной боли. Положительный результат является основой для проведения более точных и более длительных диагностических процедур.
• Диагностика СКВ. Анализ назначается пациентам с характерными клиническими проявлениями: боль в мышцах и суставах, сыпь, одышка, нарушения ритма сердца, отеки.
• мониторинг СКВ. Определение АТ периодически проводится для выяснения активности патологии, составления прогноза, оценки эффективности лечения.
• Диагностика красной волчанки. Тест проводится у пациентов, принимающих препараты, которые могут вызвать синдром волчанки.
Определение антиядерных антител с помощью иммуноблоттинга и REIT используется более узко. показания к применению:
• Дифференциация аутоиммунных заболеваний. Цель исследования - выявить СКВ, синдром Шарпа, синдром Шегрена, склеродермию, полимиозит, дерматомиозит, ревматоидный артрит, первичный билиарный цирроз и первичный склерозирующий холангит. В основе лежит высокий уровень антител против ядерных антигенов (ИФА), против выделенного ядерного антигена, против ДНК, против нуклеосом в сочетании с характерной клинической картиной.
• Мониторинг ревматических заболеваний. Тест проводится для выявления обострений, оценки течения и эффективности лечения артрита, остеоартрита, васкулита и диффузных заболеваний соединительной ткани.
• Скрининг на коллагеноз. Тест используется для обследования людей с риском неспецифических и легких симптомов: усталости, лихорадки, головной боли. Положительный результат является основой для проведения более точных и более длительных диагностических процедур.
• Диагностика СКВ. Анализ назначается пациентам с характерными клиническими проявлениями: боль в мышцах и суставах, сыпь, одышка, нарушения ритма сердца, отеки.
• мониторинг СКВ. Определение АТ периодически проводится для выяснения активности патологии, составления прогноза, оценки эффективности лечения.
• Диагностика красной волчанки. Тест проводится у пациентов, принимающих препараты, которые могут вызвать синдром волчанки.
Определение антиядерных антител с помощью иммуноблоттинга и REIT используется более узко. показания к применению:
• Дифференциация аутоиммунных заболеваний. Цель исследования - выявить СКВ, синдром Шарпа, синдром Шегрена, склеродермию, полимиозит, дерматомиозит, ревматоидный артрит, первичный билиарный цирроз и первичный склерозирующий холангит. В основе лежит высокий уровень антител против ядерных антигенов (ИФА), против выделенного ядерного антигена, против ДНК, против нуклеосом в сочетании с характерной клинической картиной.
• Мониторинг ревматических заболеваний. Тест проводится для выявления обострений, оценки течения и эффективности лечения артрита, остеоартрита, васкулита и диффузных заболеваний соединительной ткани.
Подготовка
Уровень АНА определяется в венозной крови. Ваш забор производится утром, никакой специальной подготовки не требуется, но вы должны соблюдать общие правила:
• Поддерживать 4-6-часовой период голода. Питьевая вода разрешена без ограничений.
• Ограничьте потребление жирной пищи накануне вечером в течение дня, чтобы отказаться от алкогольных напитков для интенсивных физических нагрузок. Избегайте влияния стрессовых факторов.
• Через 7-10 дней расскажите своему врачу о лекарствах, которые вы используете. Ваше действие будет учтено при интерпретации результата.
• Физиотерапевтические процедуры, инструментальные обследования, выполняемые после сдачи крови.
• В течение 30 минут воздерживаться от курения, умеренных физических нагрузок.
Кровь собирается в локтевой вене и отправляется в лабораторию в герметичной пробирке. Предварительно сыворотку выделяют из первичного биоматериала. При определении общего количества антиядерных антител проводят иммуноферментный анализ; при изучении их разновидностей иммуноблот, косвенная иммунофлуоресцентная реакция. В первом случае результат готовится за 1 день, во втором - через 8 дней.
• Поддерживать 4-6-часовой период голода. Питьевая вода разрешена без ограничений.
• Ограничьте потребление жирной пищи накануне вечером в течение дня, чтобы отказаться от алкогольных напитков для интенсивных физических нагрузок. Избегайте влияния стрессовых факторов.
• Через 7-10 дней расскажите своему врачу о лекарствах, которые вы используете. Ваше действие будет учтено при интерпретации результата.
• Физиотерапевтические процедуры, инструментальные обследования, выполняемые после сдачи крови.
• В течение 30 минут воздерживаться от курения, умеренных физических нагрузок.
Кровь собирается в локтевой вене и отправляется в лабораторию в герметичной пробирке. Предварительно сыворотку выделяют из первичного биоматериала. При определении общего количества антиядерных антител проводят иммуноферментный анализ; при изучении их разновидностей иммуноблот, косвенная иммунофлуоресцентная реакция. В первом случае результат готовится за 1 день, во втором - через 8 дней.
Нормальные значения
Обычно АНА в плазме отсутствуют или определяются в небольших количествах, не влияя на функцию тканей. Отрицательный результат выражается по-разному в зависимости от того, как проводится тест:
• ИФА - 0-1,0 U, «отрицательный».
• Иммуноблот - «не обнаружено» (общий вывод / для каждого типа ТП).
• RNIF - менее 1: 160.
На конечный показатель не влияют физиологические факторы. Нормальный результат не исключает заболевания, но снижает риск патологии.
• ИФА - 0-1,0 U, «отрицательный».
• Иммуноблот - «не обнаружено» (общий вывод / для каждого типа ТП).
• RNIF - менее 1: 160.
На конечный показатель не влияют физиологические факторы. Нормальный результат не исключает заболевания, но снижает риск патологии.
Оценка результатов
Интерпретация увеличенной оценки теста зависит от метода исследования. При определении уровня общего АНА причинами увеличения его концентрации являются:
• Аутоиммунные заболевания. Положительный результат выявляет СКВ, ревматоидный артрит, синдром Шегрена, склеродермию, сахарный диабет 1 типа, полимиозит, дерматомиозит, миастению, щитовидную железу и печень.
• Инфекции. Повышенную ценность определяют у людей с туберкулезом, вирусным гепатитом, подострым бактериальным эндокардитом, ВИЧ-инфекцией.
• онкопатология. Образование ANA более характерно для рака легких и печени.
• лекарства. Скорость теста увеличивается с использованием ингибиторов АПФ, бета-блокаторов, гидралазина, пропилтиоурацила, хлорпромазина, лития, карбамазепина, фенитоина, изониазида, миноциклина, гидрохлоротиазида, ловастатина, симвастатина.
При анализе с определением типа антиядерных антител интерпретируется увеличение индивидуальных показателей. Когда выполняется иммуноблот, происходит разделение видов AT. В RNIF доминирующие антитела обнаруживаются по природе свечения. Отклонениями от нормы могут быть LES, синдром Шарпа, синдром Шегрена, склеродермия, ревматоидный артрит, синдром волчанки у новорожденных, полимиозит, изолированный синдром Рейно, волчанка, синдром КРЕСТ, полимиозит, полимиозит, дерматомиозит, красная волчанка, билиарный цирроз.
• Аутоиммунные заболевания. Положительный результат выявляет СКВ, ревматоидный артрит, синдром Шегрена, склеродермию, сахарный диабет 1 типа, полимиозит, дерматомиозит, миастению, щитовидную железу и печень.
• Инфекции. Повышенную ценность определяют у людей с туберкулезом, вирусным гепатитом, подострым бактериальным эндокардитом, ВИЧ-инфекцией.
• онкопатология. Образование ANA более характерно для рака легких и печени.
• лекарства. Скорость теста увеличивается с использованием ингибиторов АПФ, бета-блокаторов, гидралазина, пропилтиоурацила, хлорпромазина, лития, карбамазепина, фенитоина, изониазида, миноциклина, гидрохлоротиазида, ловастатина, симвастатина.
При анализе с определением типа антиядерных антител интерпретируется увеличение индивидуальных показателей. Когда выполняется иммуноблот, происходит разделение видов AT. В RNIF доминирующие антитела обнаруживаются по природе свечения. Отклонениями от нормы могут быть LES, синдром Шарпа, синдром Шегрена, склеродермия, ревматоидный артрит, синдром волчанки у новорожденных, полимиозит, изолированный синдром Рейно, волчанка, синдром КРЕСТ, полимиозит, полимиозит, дерматомиозит, красная волчанка, билиарный цирроз.